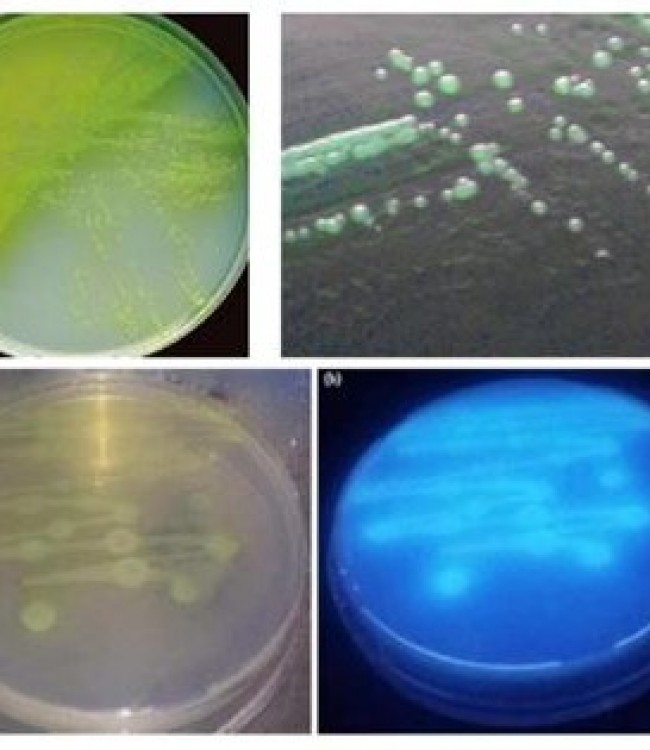
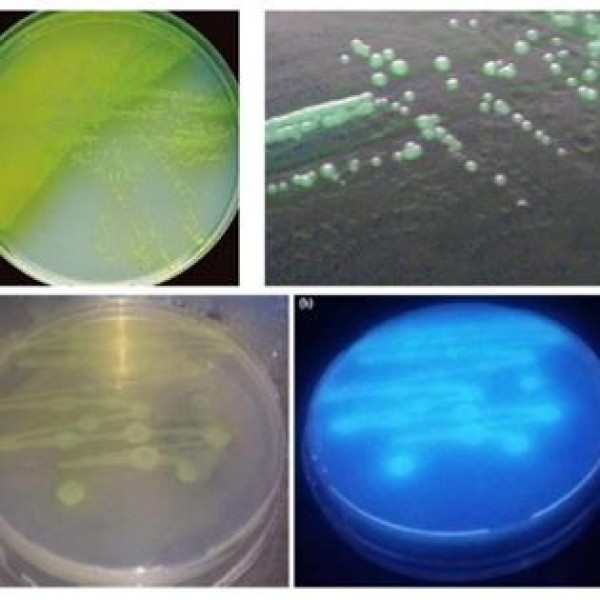

Pseudomonas Selective Agar, Base (Cetrimide Agar)
Pseudomonas Selective Agar, Base (Cetrimide Agar)
PSEUDOMONAS AERUGINOSA TESPİTİ
Pseudomonas aeruginosa bu besiyerinde 35 C'de +-2 aerobik koşullarda 24-48
saat inkübasyondan sonra sarı-yeşil pigmentli koloni oluşturur ve uzun
dalga boylu UV lambası ile floresan ışıma verir.